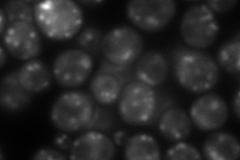
YDR170C
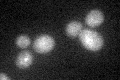
YDR170C

View description
Guanine nucleotide exchange factor (GEF) for ADP ribosylation factors involved in proliferation of the Golgi, intra-Golgi transport and ER-to-Golgi transport; found in the cytoplasm and on Golgi-associated coated vesicles
Localization:
Intensity:
Fold change:
Significance:
-
C’ GFP library in SD

below threshold16.36 -
N' NOP1pr-GFP in SD

punctate201.068 -
N' TEF2pr-mCherry in SD
punctate207.286 -
N' NATIVEpr-GFP in SD

punctate64.5612 -
N' TEF2pr-VC and Cyto-VN in SD

punctate77.6966 -
C’ GFP library in SD+DTT
cytosol14.940.91No -
C’ GFP library in SD+H2O2

cytosol16.391No -
C’ GFP library in Starvation Media

cytosol16.431No -
C’ GFP library on the background of Pup2-DaMP

below threshold -
C’ GFP library on the background of CCT mutant

below threshold14.18210.866452No
